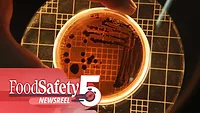
the bacterium Klebsiella pneumoniae

Food Safety Five Ep. 15: Listeria Biofilms, Seafood Import AMR, and AI Mycotoxin Detection
This episode of Food Safety Five discusses three recent studies that examine the risk of Listeria monocytogenes growth from multi-species biofilm contamination, how imported seafood may spread antibiotic resistance genes, and a promising AI mycotoxin detection method.
News Articles:
- Listeria From Multispecies Biofilms More Prone to Growth in RTE Foods, Study Shows
- Using AI, Researchers Offer Promising Real-Time Mycotoxin Detection Method for Foods
- Study: U.S. Seafood Imports are Capable of Spreading Resistance to Last-Resort Antibiotics
Image credit: Freepik
Looking for quick answers on food safety topics?
Try Ask FSM, our new smart AI search tool.
Ask FSM →